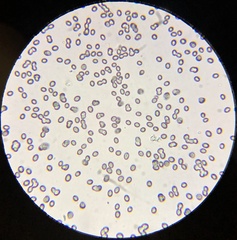
Tricholoma aestuans
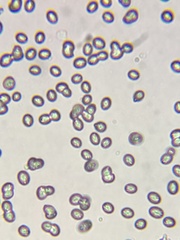
Tricholoma aestuans

Tricholoma aestuans: taxon details and analytics
- Domain
- Kingdom
- Fungi
- Phylum
- Basidiomycota
- Class
- Agaricomycetes
- Order
- Agaricales
- Family
- Tricholomataceae
- Genus
- Tricholoma
- Species
- Tricholoma aestuans
- Scientific Name
- Tricholoma aestuans
Summary description from Wikipedia:
Tricholoma aestuans
Tricholoma aestuans is a mushroom of the agaric genus Tricholoma. First described formally by Elias Magnus Fries in 1821, it was transferred to the genus Tricholoma by Claude Casimir Gillet in 1874.
...Tricholoma aestuans in languages:
- Bokmål
- bitter riddermusserong
- Czech
- čirůvka sálající
- Danish
- Kegle-ridderhat
- Dutch
- Scherpe gele ridderzwam
- Estonian
- Kirbe heinik
- Finnish
- äikävalmuska
- Hungarian
- epeízű pereszke
- Lithuanian
- Raukšlėtasis baltikas
- Swedish
- bitter riddarmusseron
Images from inaturalist.org observations:
We recommend you sign up for this excellent, free service.
Parent Taxon
Sibling Taxa
- Tricholoma aestuans
- Tricholoma argenteum
- Tricholoma atrodiscus
- Tricholoma atrofibrillosum
- Tricholoma bresadolanum
- Tricholoma chrysophyllum
- Tricholoma citrinum
- Tricholoma columbetta
- Tricholoma eosinobasis
- Tricholoma equestre
- Tricholoma frondosae
- Tricholoma griseoviolaceum
- Tricholoma guldeniae
- Tricholoma intermedium
- Tricholoma joachimii
- Tricholoma mastoideum
- Tricholoma olivaceoluteolum
- Tricholoma palustre
- Tricholoma portentosum
- Tricholoma pullum
- Tricholoma qiaomianjun
- Tricholoma rufenum
- Tricholoma sciodes
- Tricholoma sejunctum
- Tricholoma serratifolium
- Tricholoma sinoportentosum
- Tricholoma subacutum
- Tricholoma subluteum
- Tricholoma subsejunctum
- Tricholoma ulvinenii
- Tricholoma umbonatum
- Tricholoma virgatum
- Tricholoma viridilutescens
- Tricholoma yatesii